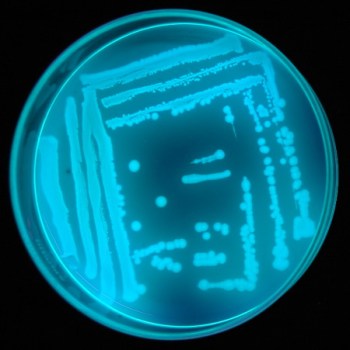
Pseudomonas sp

Many people are often wrong in perception when using chemical fertilizers, bio-fertilizers and organic fertilizers. Organic fertilizers and bio-fertilizers is often equated with chemical fertilizers. Every kind of those fertilizers is very different.
Read:
Make Granule Organic Fertilizer| Make Your own organic fertilizer |Secret of biofertilizer making
Chemical Fertilizer
As the name suggests, chemical fertilizers are fertilizers made of chemically or also commonly referred to as artificial fertilizers. Chemical fertilizers can be divided into single chemical fertilizers and chemical fertilizer compound. Single chemical fertilizers have only one kind of nutrient, while the compound chemical fertilizers contain a complete nutrient. Chemical fertilizers are often used include urea and ZA for the N nutrient; fertilizers TSP, DSP, and SP-26 for the P nutrient, KCl or MOP for the K nutrient. While compound fertilizers are usually made by mixing a single fertilizers. Nutrient composition varies, depending on the manufacturer and commodities.
Organic Fertilizer

Kompos, pupuk organik yang murah dan mudah dibuat. Baca: Make compost straw
Organic fertilizers, such as the name suggests, is a fertilizer made from organic materials or natural. Fertilizers including organic fertilizers include manure, compost, kascing, peat, seaweed and guano. Based on the form of organic fertilizers can be classified into solid organic fertilizer and liquid organic fertilizer. Some people also classify the fertilizers such as dolomite mined, natural phosphate, kiserit, and also ash (rich in K) to the group of natural fertilizer / organic. Some organic fertilizers are processed at the plant for example is a blood meal, bone meal and fish meal. Liquid organic fertilizers include compost tea, plant extracts, fermentation liquid sewage farms, fermentation plants, and others.
Organic fertilizers contain a complete nutrient. Even in the organic fertilizer is also organic compounds that are beneficial to other plants, such as humic acid, acid fulvat, and others. However, the nutrient content are quite low. Based on my experience, there is no organic fertilizer that has a high nutrient content, or nearly equals with the chemical fertilizers.
People often calculated the needs of organic fertilizer based only on their nutrient content. Nutrient content of organic fertilizer synchronized with the nutrient content of chemical fertilizers used. As a result of organic fertilizer needs so many times compared with the dose of chemical fertilizers. For example compost with the following content: 2.79% N, 0.52% P2O5, 2:29% K2O. So in 1000 kg (1 ton) of compost will be equivalent to 62 kg of urea, 14:44 kg SP 36, and 38.17 kg of MOP. It is calculated as follows:
N =
(% N Compost x 1000 kg) /% N Urea = (2.79% x 1000 kg) / 45% = 62 kg
P =
(% P2O5 compost x 1000 kg) /% P2O5 SP-36 = (0.52% x 1000 kg) / 36% = 14:44 kg
K =
(% K2O compost x 1000 kg) /% K2O MPO = (2:29% x 1000 kg) / 60% = 38.17 kg
For example, rice is usually given a dose of chemical fertilizer with 200 kg urea, 100 kg SP-36, and 150kg MOP / KCl. In order to match the nutritional content of the compost as much as needed approximately 7 tons. This large dose will direct implications for the cost of fertilization. If the calculated cost of fertilizing with organic fertilizer / compost much greater than the cost of fertilization with chemical fertilizers. This does not include costs for the compost application.
Reality on the ground proves that organic fertilizer / compost can not be calculated based on nutrient content only. If you do not believe you can do a simple experiment to compare these two fertilizers. Take the soil, you should use marginal soil. Enter into the two polybag and its contents are the same size. One polybag given dose of compost with 0.5 – 1 kg. Polybag others are given a few spoonfuls of fertilizer chemicals, approximately equal in nutrient content with compost. Then planting any crops, can chili beans, tomatoes, cay sim, cucumber, or other plants. Put in the same place. Give the same treatment watering, weeding, and other similar treatment. Wait a while until the plants grow and produce. Just compare, where the plants a better result?

Simple way to test chemical fertilizers, organic fertilizers and bio-fertilizers. (A) control, no fertilization at all. Plants look very miserable. (B) Given the chemical fertilizer, plants still languish even grow better. (C) Given the compost / organic fertilizer. The result is much better. (D) be given organic fertilizer / compost and biofertilizer, the best growth.
I am almost 90% sure that if given a compost plant will grow better than plants given chemical fertilizer, although comparable nutrient content. The next question is WHY??
People often forget that in addition to nutrient content, organic fertilizers also contain otherorganic compounds. Although low in nutrient content but the content of organic compounds in the compost has a more important role than the role of nutrient alone. For example, humic acid and acid fulvat. Both these acids have a role as a hormone like that can stimulate plant growth. Compost is known to increase the value of CEC (cation exchange capacity) of land. This means that the plant will more easily absorb nutrients. Be composted soil also becomes more friable and soil aeration for the better. Land is given more compost and water saving is not easy to dry. If further observed, the activity of soil microbes in compost would be higher than the land not be composted. These microbes have a role in nutrient absorption by plants. It can be conclused, compost can improve the chemical properties, physical properties, and biological soil properties.
Then how to calculate the needs of organic fertilizer / compost?
Until now I have not found the formula, both from my own experience or from the literature of others, to calculate the needs of organic fertilizer / compost it. Content of organic fertilizer is very diverse. Characteristics also vary. Equally manure, manure at P Java could be very different from the manure P Sulawesi. Not to mention the relationship with soil type, climate, environmental conditions, how crops cultivation and different. Generally organic manure / compost is empirically determined. This is the result of research and testing. May also experience the farmers field for many years.

Examples of organic fertilizer granules form in the market.
Under certain conditions, organic fertilizer / compost can be provided without adding chemical fertilizers at all. This method is practiced in organic cultivation. More often done is to combine the organic fertilizer with chemical fertilizer. Some substituted plant nutrient needs of chemical fertilizers and organic fertilizers. How to calculate the most economical combination of both viewed from the cost and outcome. The rule is often used is 50% dose of chemical fertilizers replaced with a number of organic fertilizer. Dose can 1 to 2 kg or even up to 30 kg / principal..
To get the most appropriate dose in trials conducted in the greenhouse and in the field in a fairly large scale.
.
Read: Kompos jerami: murah, mudah, dan cepat | Video Pengomposan Jerami
Biofertilizer

Example import biofertilizer in liquid form.
Link terkait: Penjelasan tambahan tentang mikroba untuk memperkaya kompos
Cool name of bio-fertilizers is biofertilizer. There are also called bio fertilizer. Whatever the name of biological fertilizers can be interpreted as a living fertilizer. Actually the name of fertilizer is less suitable, because bio-fertilizers do not contain nutrients. Bio-fertilizers do not contain N, P, and K. Content of bio-fertilizers is mikrooganisme have a positive role for the plant. Group of microbes that are often used are microbes that attach N from the air, microbes that dissolve nutrients (especially P and K), microbes that stimulate plant growth.
N fixing microbial groups has been known and used since long. Microbes have a fix N symbiotic with plants and some are free (not symbiotic). Examples of microbes with plants symbiosis include Rhizobium sp As examples of microorganisms that are not anchor N is Azosprillium sp bersimbiosis and Azotobacter sp.

Rhizobium colonies growing in agar medium.

Rhizobium viewed under a microscope with a magnification 30.000x

Form of an infected root nodule Rhizobium.

Active nodule will be split if the blood-red (left), whereas the inactive nodule pale (right)
Solvent microbial P was reported by a Russian named Pikovskaya in 1948 is Bacillus Megatherium var. phosphaticum, and began to be used as an inoculum of agriculture since the 1950s Some microbes are known to dissolve P from the sources found difficult to dissolve either from the mold / fungi such as Penicillium sp and Aspergillus sp, or of groups of bacteria such as Bacillus and Pseudomonas sp sp.

Phosphates solubilizing Bacteria

Phosphates solubilizing fungi

Phosphate solubilizing microbes used to enrich the natural phosphate. Natural phosphate granules in the photo above was enriched with phospate solubilizing microbes.
Baca juga: Mikroba Pelarut Fosfat untuk Memenuhi Kebutuhan Pupuk Fosfat
Other microbes that are often used are Mycorhiza, which consists of two main groups namely: endomycorhiza and ektomycorhiza. Arbuscular assiciated with plants. Simply way, endomycorhiza means that there is in and ektomycorhiza outside. Endomikoriza or VAM fungi generally is low level while the fungus ektomikoriza is a high level. Mycorhiza have done a pretty complex. Its was not only part to help the absorption of nutrients P, but also protects plants from disease and provide other nutrients for plants.

Mycorhiza
Microbes are also often used as a microbial biofertilizer plant growth stimulants. Microbes from the group of bacteria is often referred to as Plant Growt Promoting Rhizobacteria (PGPR), but now also known that there are also fungi that can stimulate plant growth. Bacteria are known to stimulate plant growth include Pseudomonas sp, sp Azosprillium, while the well-known fungi are Trichoderma sp.
Pseudomonas sp, one of PGPR bacteria that produce hormones.
Microbes active ingredients of biological fertilizers packaged in carrier materials, can be in liquid or solid. There are also bio-fertilizers which only consists of one or a few microbes, but there is also a claim consists of a variety of microbes. This bio-fertilizers which was then applied to the plants.
Currently circulating in the market many bio-fertilizers. Some claim to have a lot of microbial content and complete with extraordinary abilities. Personally I do not believe in having a lot of biofertilizer microorganisms and effective in all places, all commodities, and all conditions.
One disadvantage of microorganisms is highly dependent with a lot of things. Microbes are influenced by environmental conditions, both biotic and abiotic environment. So a suitable biofertilizer in sub-tropical regions is not necessarily effective in the tropics. Similarly effective biofertilizer in the western part of Indonesia, may not be effective also in the eastern part of Indonesia. Microbial associated with more specific plants. Eg Rhizobium sp associated with certain varieties of soybeans may not be suitable for crop beans other. Symbiotic microbes generally narrow spectrum.
Recent Trend
Bio-fertilizers, organic manure and chemical fertilizers are fertilizers which firm difference. But this time there is a tendency to combine the types of fertilizer. For example there is the fertilizer product calling itself organic NPK fertilizer. These fertilizers are chemical fertilizers combined with organic fertilizer. There is also a call for bioorganic fertilizer. The point is the combination of organic fertilizer with bio-fertilizers (bio). But there is still little or no fertilizer NPK combined with bio-fertilizers. Because most microbes can not stand when combined with chemical fertilizer in high concentrations.
So a lot of fertilizer products in the market. It’s up to you to choose which one. I suggest you choose a bio-fertilizers or organic fertilizers if possible. Since both fertilizer is far more environmentally friendly.
DOWNLOAD PUPUK ORGANIK
Silahkan didownload resources yang mungkin Anda perlukan juga:
- Buku Petunjuk Pupuk Organik Granul
- Buku Petunjuk Teknis Lapang Pengelolaan Tanaman Terpadu (PTT): Padi Sawah Irigasi
- Petunjuk Teknis Uji Mutu Pupuk Organik
- Standard Mutu Pupuk Organik
- Kompos
- SNI Dolomit
- Kompos Limbah Kakao
- Petunjuk Lapang PTT Padi
- Budidaya Padi Sehat
- Brosur Budidaya Padi Sehat
- Brosur Kompos Jerami
- Pengelolaan Lahan untuk Budiaya Sayur Organik
- Pupuk Organik dan Pupuk Hayati
- Sifat Fisik Tanah dan Metode Analisisnya
- Analisis Biologi Tanah
- Juknis Mutu Pupuk Organik
- Menuju Pertanian Lahan Kering Lestari
- Pembuatan Kompos-Balittanah
- Pemupukan Berimbang
- Sifat Fisik Tanah dan Metode Analisisnya
- Petunjuk Pengambilan Sampel Tanah untuk Analisis Biologi Tanah
- Compost Quality TestGermination Index Method
- Compost and Soil Conditioner Quality Standards 2005
Daftar bahan lain yang bisa didownload: Download Di Sini
Cara mendownload: Klik dua kali pada link yang akan didownload. Kemudian ikuti perintah selanjutnya. Kalau ada iklan yang muncul, klik aja iklannya atau langsung ke SKIP ADD yang ada di pojok kanan atas.








SKSbio is the Biotechnology Company In india Ap.we are involved in the production of Bioproducts,biofertilizers,probiotics and enzymes,effluent treatment products.